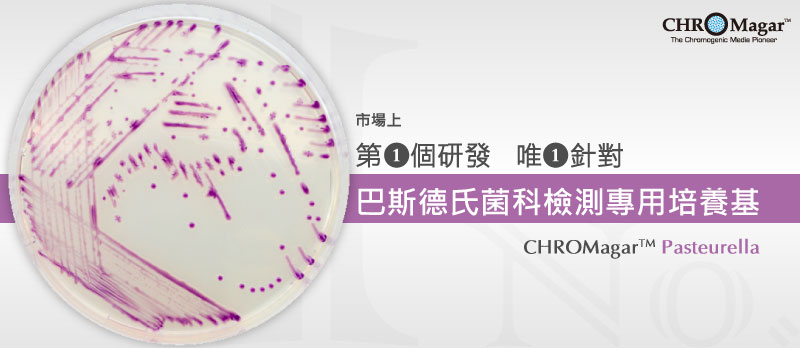
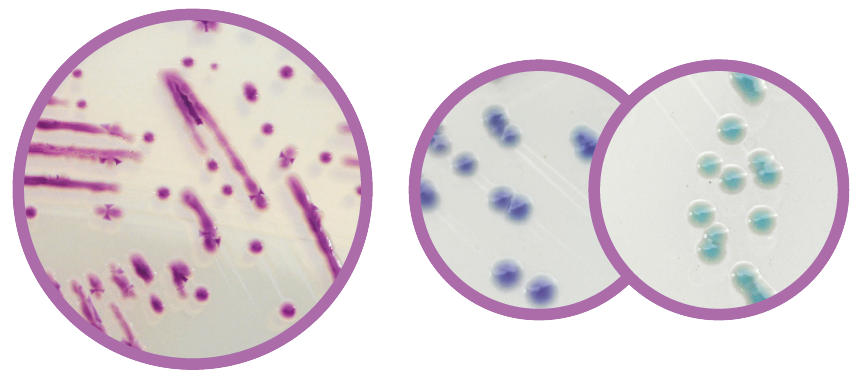

2021/08/25 新推出-巴斯德氏菌科檢測專用培養基
|
| 巴斯德氏菌科(Pasteurellaceae)檢測專用培養基 |
|
巴斯德氏菌科是和許多脊椎動物中上呼吸道共生的菌群。其中Histophilus somni、Pasteurella multocida及Mannheimia hemolytica 是造成呼吸道感染的主要病原菌;而此種感染尤其在牛群中影響很大,可能會導致他們生長速度遲緩、產乳量下降,甚至死亡。 |
| 判 讀 |
|
| Pasteurellaceae E.coli / Coliforms |
| 獸醫的運用 |
 |
| 鼻咽拭子(Nasal swab)、 氣管穿刺抽吸液(trans-tracheal aspiration/TTA)、 支氣管灌洗術(bronchial lavages)、肺檢體(lung samples) |
| 為什麼選擇 CHROMagarTM Pasteurella? |
|
►獨一無二的呈色培養基:
市場上第一個適用於巴斯德氏菌的專一性培養基。
►工作量的降低: 能透過獨特淡紫色菌落,與其他細菌區分。 ►選擇性的提高: 能夠抑制大多數的環境菌群。 ►及早平板判讀: 大部分的菌株在隔夜培養後,會出現明顯的菌落。 |













